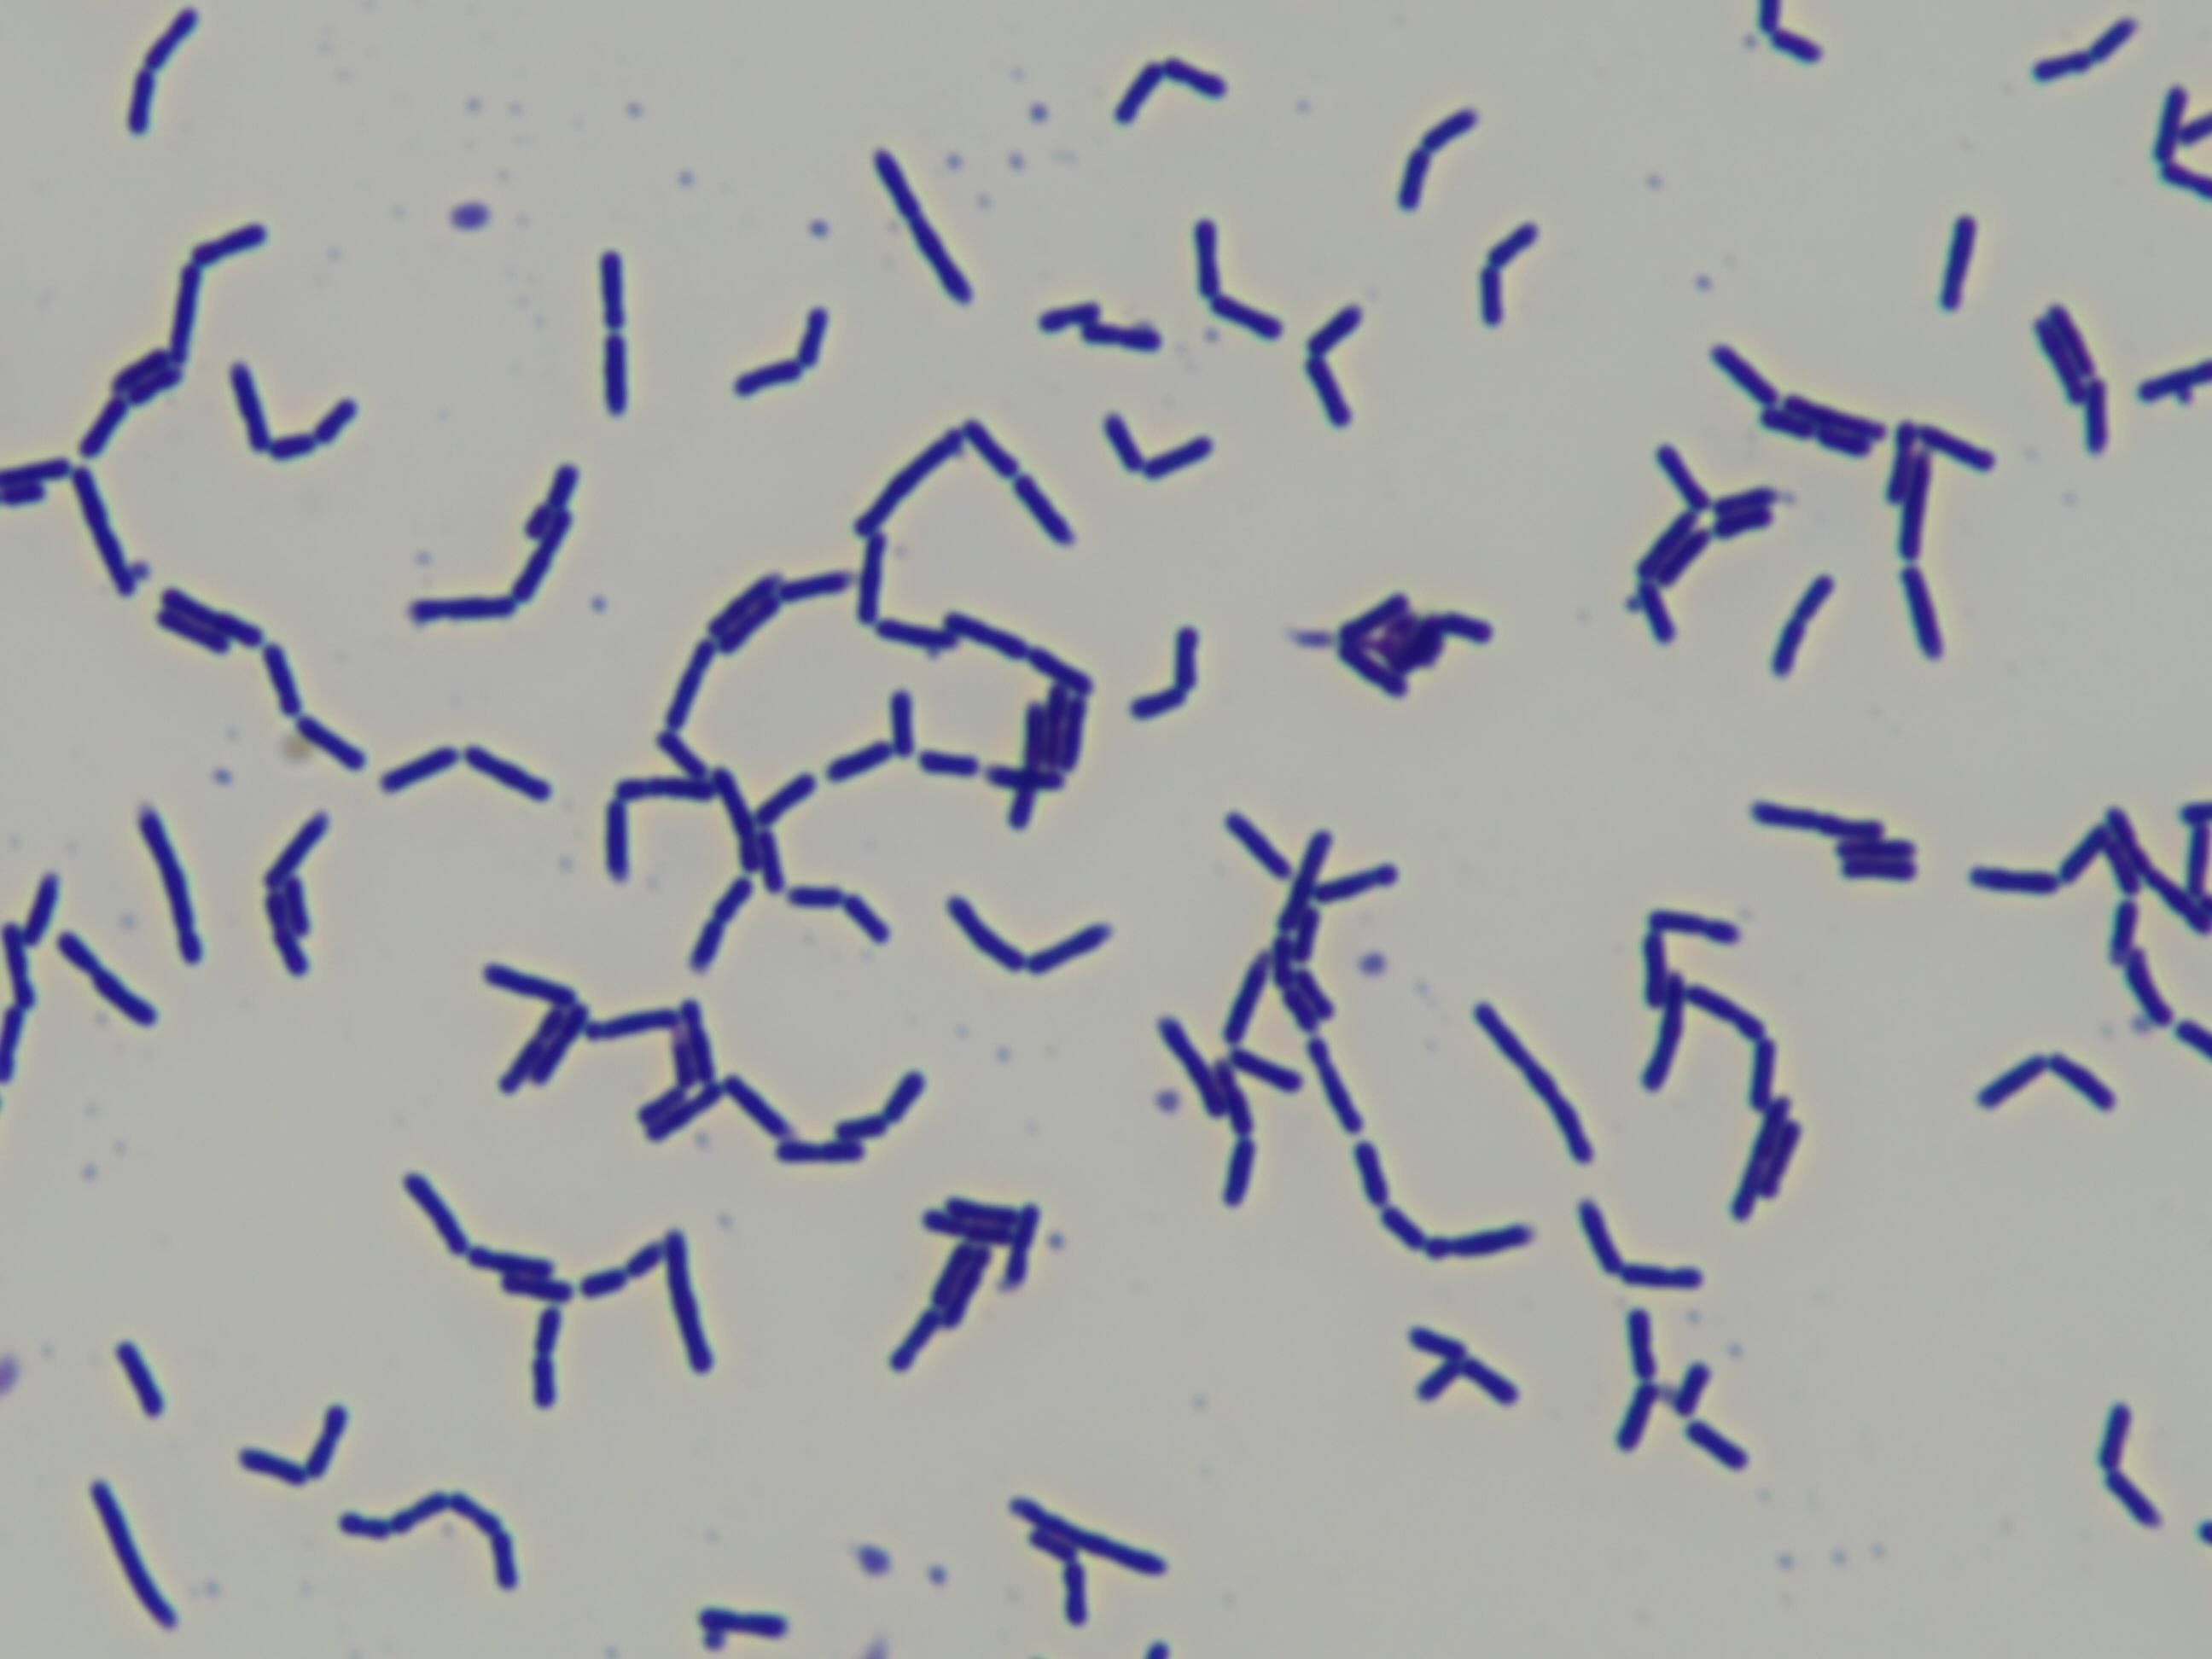

Lacticaseibacillus casei
Product description
Lacticaseibacillus casei formerly known as Lactobacillus casei, is a gram-positive, rod-shaped bacterium that plays a significant role as a probiotic. It is commonly found in the human digestive tract and is known for its ability to produce lactic acid, which contributes to gut health by lowering pH levels and inhibiting harmful bacteria.
Read more
Specifications
| Categories | Fungi & Yeasts, Microorganisms & Probiotics, Mushrooms | Microorganisms & ProbioticsOther Microorganisms & Probiotics; Digestive Health |
|---|---|
| Supplied from | India |
Products from other suppliers
❮
❯
-

Sea Cucumber & Oyster Tablet
-

Bifidobacterium longum BORI
-

Pep2Dia®, new bioactive ingredient that regulates blood sugar levels after meals.
-

CRISPYTEC Series
-

GLP-1 Probiotics - Akkermansia muciniphila AH39 & Lactobacillus casei CCFM419
-

BiPRO® 9500 whey protein isolate (WPI)
-

Crispact® Stick packs
-

Nextida® GC
-

Gasbet tablets
-

NEUROMAX®
Lacticaseibacillus casei